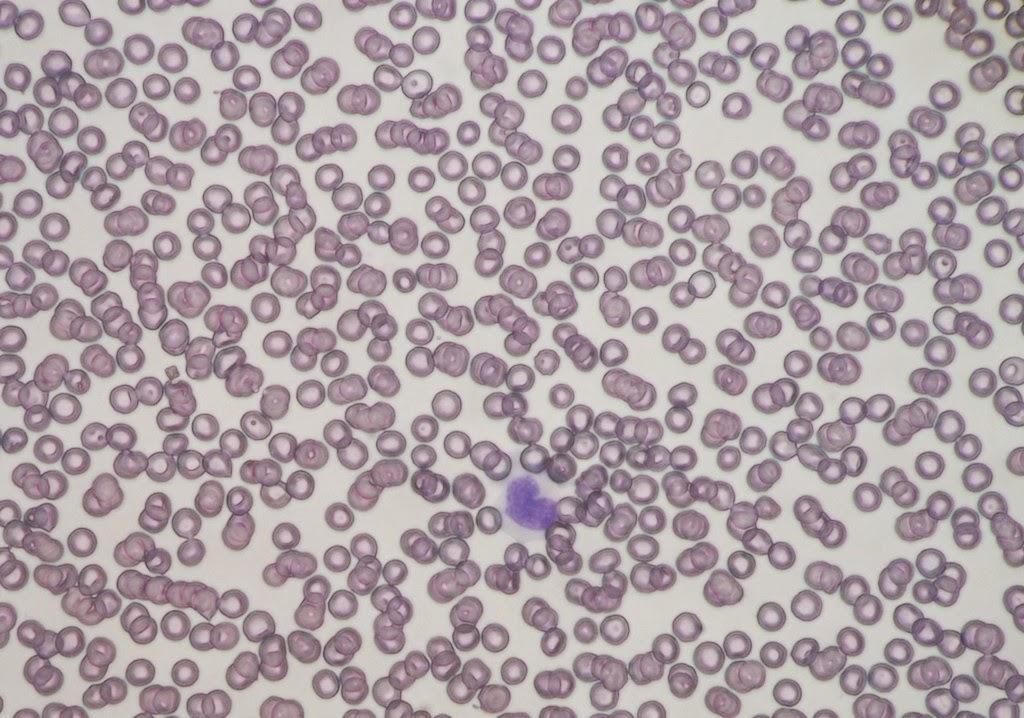
Foto 2

Vet Análises - Laboratório Veterinário de Análises Clínicas
Centro Pelotas RS
(1 avaliações)
Por que escolher Vet Análises - Laboratório Veterinário de Análises Clínicas? É uma boa opção em Pelotas, com nota média de 4 estrelas.
Serviços oferecidos:
Clínica Veterinária
Veterinary Clinic
Faça login para deixar sua avaliação
Entrar
Ver Endereço
Rua Voluntários da Pátria, nº 664, Centro, Pelotas, RS
Ver Telefone
(53) 30252-030
Como Chegar
Prestador não existe
Pet Shops Próximos

Inspetoria Veterinaria
Centro Pelotas RS
Novo

Médico Veterinário a Domicilio
Centro Pelotas RS
(1)

Mika
Centro Pelotas RS
(5)